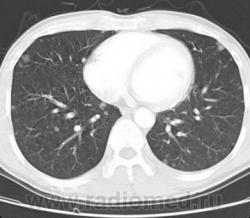
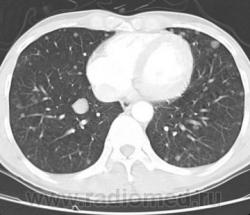

Пол пациента:
Тип патологии:
Область исследования:
Методы исследования:
- https://radiomed.ru/sites/default/files/styles/case_slider_image/public/user/12/2.c.risunok28.jpg?itok=ec5IUwzx
- https://radiomed.ru/sites/default/files/styles/case_slider_image/public/user/12/3.c.risunok29.jpg?itok=YSKeDbeH
- https://radiomed.ru/sites/default/files/styles/case_slider_image/public/user/12/4.c.risunok30.jpg?itok=RfCVrCgJ
- https://radiomed.ru/sites/default/files/styles/case_slider_image/public/user/12/5.c.risunok31.jpg?itok=pPmNwgyw
- https://radiomed.ru/sites/default/files/styles/case_slider_image/public/user/12/6.c.risunok32.jpg?itok=wheeJv-r
- https://radiomed.ru/sites/default/files/styles/case_slider_image/public/user/12/7.c.risunok33.jpg?itok=SBzR_bjQ
- https://radiomed.ru/sites/default/files/styles/case_slider_image/public/user/12/8.c.risunok34.jpg?itok=dhYkxqno
- https://radiomed.ru/sites/default/files/styles/case_slider_image/public/user/12/1.c.risunok11.jpg?itok=eetTnnTW
- https://radiomed.ru/sites/default/files/styles/case_slider_image/public/user/12/2.c.risunok12.jpg?itok=ij4UhI_V
- https://radiomed.ru/sites/default/files/styles/case_slider_image/public/user/12/3.c.risunok13.jpg?itok=m2Rvm3Xe
- https://radiomed.ru/sites/default/files/styles/case_slider_image/public/user/12/4.c.risunok14.jpg?itok=h7jBH3fa
- https://radiomed.ru/sites/default/files/styles/case_slider_image/public/user/12/5.c.risunok15.jpg?itok=zwl25eJF
- https://radiomed.ru/sites/default/files/styles/case_slider_image/public/user/12/6.c.risunok16.jpg?itok=RJ_WK0If
- https://radiomed.ru/sites/default/files/styles/case_slider_image/public/user/12/7.c.risunok17.jpg?itok=6EXV71eE
- https://radiomed.ru/sites/default/files/styles/case_slider_image/public/user/12/8.c.risunok18.jpg?itok=HxROQzeZ
- https://radiomed.ru/sites/default/files/styles/case_slider_image/public/user/12/1.c.risunok19.jpg?itok=xmieGSAd
- https://radiomed.ru/sites/default/files/styles/case_slider_image/public/user/12/2.c.risunok20.jpg?itok=gjhIhNeX
- https://radiomed.ru/sites/default/files/styles/case_slider_image/public/user/12/3.c.risunok21.jpg?itok=k4IBLJJ_
- https://radiomed.ru/sites/default/files/styles/case_slider_image/public/user/12/4.c.risunok22.jpg?itok=fcHawwS-
- https://radiomed.ru/sites/default/files/styles/case_slider_image/public/user/12/5.c.risunok23_0.jpg?itok=ktWyWAga
- https://radiomed.ru/sites/default/files/styles/case_slider_image/public/user/12/6.c.risunok24.jpg?itok=v-FGS6sP
- https://radiomed.ru/sites/default/files/styles/case_slider_image/public/user/12/7.c.risunok25.jpg?itok=q8xJ_XLF
- https://radiomed.ru/sites/default/files/styles/case_slider_image/public/user/12/8.c.risunok26.jpg?itok=Rz2FA2-u
ID:10796

Судя по аксиалам - полиморфные, преимущественно округлой формы тени высокой плотности в средних и нижних отделах обоих легких (mts, туберкуломы, кисты?). А по другим проекциям?
"Тубарские дела", как правило, повыше...
Может действительно метастазы?
Как понимать "полиморфные" и "высокой плотности в средних и нижних отделах обоих легких"????????????
"Знаешь, у некоторых врачей есть комплекс мессии — им необходимо спасать мир. А у тебя комплекс Рубика — тебе необходимо решать головоломки."
Под термином "полиморфные", на мой взгляд, в классической рентгенологии понимаются "очаговые компоненты" различной формы, некоторые, также, плюсом понимают и различные размеры.
Я попытаюсь пояснить, при описание КТ, такая "рентгенологическая" терминология не используется. Просто описываем как множественные узелки.
Let me see...
radiographia.ru
Редко, но бывает при бронхогенной диссеминации (в фазе распада) распространение процесса и в нехарактерные для Tbc сегменты, особенно в нижних отделах. Но сам больше склоняюсь к mtc.
Вы правы Марио, мы в большинстве своём, здесь на сайте, рентгенологи, а соответственно, и пользуемся скиалогической терминологией. Я думаю, что в этом большого, да, и вообще никакого криминала нет.
Здравствуйте уважаемый Виталий Валерьевич!
А, Ваше мнение каково по данным изображениям?
Да, Вы правы, сам КТ не занимаюсь, вот по старинке и написал... Пользуясь случаем, хотел уточнить, в понятие "полиморфные" входят затенения обязательно разной плотности? Или это распространяется только на форму и размеры?
Я полностью согласен с Вами, уважаемый коллега!
Особенно, в последнее время, этот феномен диссеминации "атипично", все чаще, и чаще наблюдается, а у лиц преклонного возраста, стал прямо превалировать.
Валентин Львович предугадал мой вопрос. Спасибо. А то у меня тут спор активный с отцом (он у меня фтизиатр).
Я лично, дабы избежать придирок областных боссов, эти понятия разделяю. В своё время, накрепно запомнил характеристику "очаговых теней - очагов", данную Копыловым, с тех пор и пользуюсь. Хотя, авторы более позднего времени, старались внести свою лепту в эти характеристики. Очень люблю в плане посиндромки Линденбратена и Наумова, на мой взгляд, просто добавить нечего.
Под полиморфностью в классической рентгенологии понимается ни только как структурность, но и "длительность ", т.е. время происхождения того или иного очага(фокуса), наверное я приметивно поясняю, но в какой то мере с учетом синдромальности с рентгенологией с Dr.Mario следует согласиться в плане, шкалы Хаунсфилда(HU).
"Знаешь, у некоторых врачей есть комплекс мессии — им необходимо спасать мир. А у тебя комплекс Рубика — тебе необходимо решать головоломки."
Это хорошо коллега, что Вы являетесь представителем врачебной династии!
Соседство с фтизиатром "старшего поколения", всегда благотворно отзывается на молодом специалисте рентгенологе. Поздравляю Вас!
В принципе в пределах нашего сайта при обсуждениях криминала нет, главное что бы мы друг друга понимали. Но, в КТ лёгких есть своя специфическая научная международная терминология, которая обязательна к использованию при описании КТ грудной полости. См. мою публикацию по ДИЗЛ.
Let me see...
radiographia.ru
С этим, уважаемый Виталий Валерьевич не соглашусь, доже при большом уважении к Вам.
"Возраст" очага, мелкой фокусной тени, определяется интенсивностью, в ряде случаев "структурой", характеристикой контуров, состоянием ближайшего легочного окружения.
Спасибо, Валентин Львович. Вы абсолютно правы. Если позволите, приведу как раз пример с бронхогенной диссеминацией.
Конечно!
Никогда не забуду случай на первой же неделе моей работы. Молодой человек с жалобами на фебрильную температуру, кашель с обильной мокротой, боли в грудной клетке. Учитывая острое начало, молодой возраст, и не особо разбираясь в туберкулезе, я поставил двухстороннюю пневмонию, абсцесс в проекции 6-го сегмента, направил в стационар. Только после контрольных снимков направил его к отцу. После этого отец заставил меня весь вечер рисовать сегменты легких, и крепко выучить, что характерно для tbc, а что нет.
Диагноз отца - инфильтративный туберкулез левого легкого в проекции 6-го сегмента в фазе распада и бронхогенной диссеминацией в правое легкое.
Лично я, всегда, с учетом нашей эпидемиологической ситуации в районе, по образному выражению нашего уважаемого Петровича, всегда прежде всего при таких "картинках" заточен на туберкулёз. Конечно, не прилично выражаться так, на этом уважаемом сайте, но "шестерку" счатаю не меньшей "вонючкой" нежели верхушки.
Хорошие, поучительные изображения.
Спасибо.
В том и дело Валентин Львович, как правило в классической рентгенологии "полиморфность" трактуется по структуре интенсивности той или иной тени, но в КТ имеет значение, следует заметить очень большое значение "РАЗМЕРЫ" и структура оценивается ни только в режиме легочного окна представленного Вами, но и самое интересное все в режиме средостения, ибо мягко тканный компонент имеет тенденцию отображать накопления контрастного вещества.
"Знаешь, у некоторых врачей есть комплекс мессии — им необходимо спасать мир. А у тебя комплекс Рубика — тебе необходимо решать головоломки."
Спасибо Виталий Валерьевич!
Но, вернемся к нашим баранам - к данному случаю, так как пациента "пощупали", и ниже...
А ниже, наверное, типа "зла" со стороны почек или панкреас...
"Знаешь, у некоторых врачей есть комплекс мессии — им необходимо спасать мир. А у тебя комплекс Рубика — тебе необходимо решать головоломки."
Значит ещё ниже, эххх бедная предстательная
"Знаешь, у некоторых врачей есть комплекс мессии — им необходимо спасать мир. А у тебя комплекс Рубика — тебе необходимо решать головоломки."
Продолжение.
Неужели не было жалоб - такое вырастить надо суметь...
https://www.youtube.com/channel/UCBGxoBUOqUT_bFhSeUgtWEw
Как, это ни странно, может, что-то и беспокоило, но не обращался в ЛПУ. ЗАЦЕПИЛА ФЛЮШКА.
А, вот еще одна "диссеминация".
Сегодня будет выставлена прекраснейшая презентация нашего Глубокоуважаемого Анатолия Владимировича, советую Вам с ней ознакомиться, не надо будет рисовать сегменты (по поводу сегментов - шутка).
Да я уже не рисую, после того случая хоть посредь ночи...)))) Но ознакомлюсь обязательно.